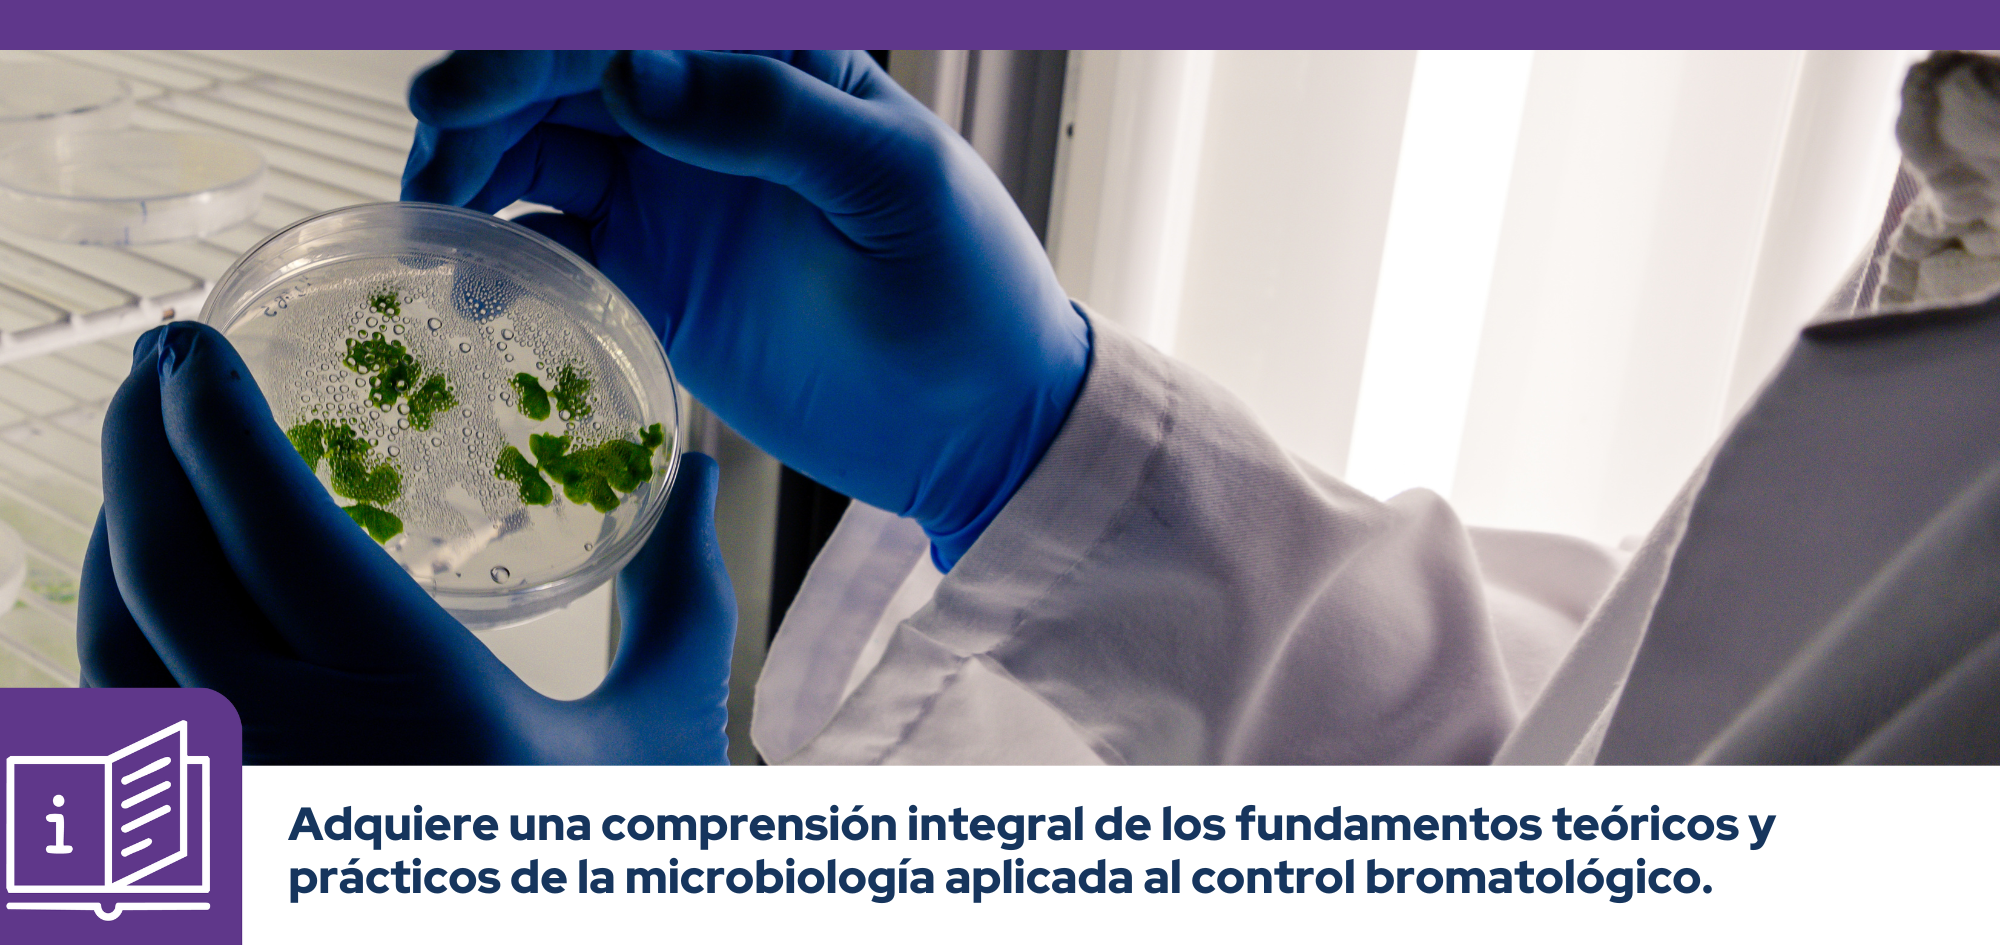

Microbiología Aplicada al Control Bromatológico
Inicio
23 de marzo
Duración
12 horas
Modalidad
Virtual
Inversión
$60,00
| Fecha de inicio: | 23 de marzo de 2026 |
|---|---|
| Fecha de fin: | 26 de marzo de 2026 |
| Horario: | lunes a jueves de 18h00 a 21h00 |
Sin existencias
La "Microbiología Aplicada al Control Bromatológico" es una formación diseñada para profesionales de la industria alimentaria, y de control sanitario.
El curso profundiza en los peligros biológicos asociados a los alimentos, las enfermedades transmitidas por alimentos (ETAs) y las técnicas para su prevención y detección. Se abordan bacterias patógenas, hongos, virus, parásitos y toxinas naturales, así como los factores intrínsecos y extrínsecos que influyen en su proliferación y calidad de vida útil.
Contenidos del programa
Unidad 1: Introducción de los principales conceptos de Microbiología y Bromatología de alimentos.
Unidad 2: Aspectos generales de los microorganismos, parámetros relacionados a la vida útil de los alimentos, Principales Microorganismos en los alimentos.
Unidad 3: Enfermedades transmitidas por los alimentos (ETAs)
Unidad 4: La Microbiología como herramienta para la verificación de la inocuidad alimentaria.
Dirigido a
Profesionales y estudiantes de bioquímica, nutrición, calidad, alimentos, veterinaria, laboratorio e higiene y seguridad alimentaria.
Certificación
Certificado de aprobación.
Estructura
4 unidades que incluyen actividades virtuales.
Requisitos
- Computador y conexión a internet.
Conoce a tus instructores/as
Con la calidad PUCE
Con el respaldo académico de la Pontificia Universidad Católica del Ecuador
Inscríbete y obtén tu certificado en
Tutor personal
Contarás con una guía constante para resolver tus dudas y completar exitosamente tu programa
Campus virtual 24/7
Recursos y materiales disponibles en el campus virtual PUCE